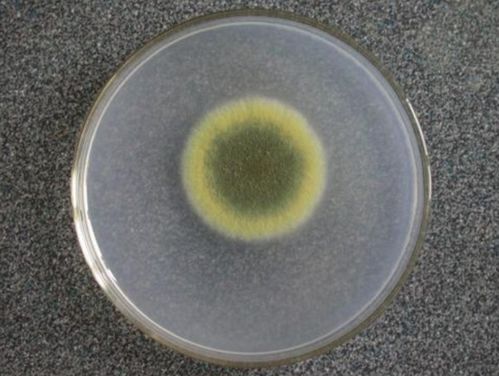

显微镜下区分毛霉、根霉、曲霉与青霉的方法
作者:佚名 来源:未知 时间:2024-10-31
显微镜下的真菌世界:毛霉、根霉、曲霉、青霉的区别

在微生物学的广阔领域中,真菌占据着举足轻重的地位。它们不仅广泛存在于我们的日常环境中,如土壤、空气、水和动植物体中,还在食品发酵、医药制造和农业生产中发挥着重要作用。然而,这些微小的生物在形态和生理特性上存在着显著差异。本文将介绍如何在显微镜下区分四种常见的真菌:毛霉、根霉、曲霉和青霉。

毛霉
毛霉,又称黑霉或长毛霉,是接合菌门、接合菌纲、毛霉目、毛霉科真菌中的一个大属。这种真菌在土壤、粪便、禾草及空气等环境中广泛存在,并以孢囊孢子和接合孢子进行繁殖。
在显微镜下观察,毛霉的菌丝呈现出无隔膜、多核、分枝状的特点。这些菌丝在基质上或基质内能够广泛蔓延,形成具有假根和匍匐枝的菌落结构。毛霉的孢囊梗直接从菌丝体生出,一般单生,分枝较少或不分枝。分枝顶端膨大形成孢子囊,囊内产生孢囊孢子。毛霉菌落通常无固定形态,颜色多变,这取决于其具体种类和培养条件。
毛霉在工业上有着广泛的应用。例如,它能够在酒药中糖化淀粉并生成少量乙醇,还能产生蛋白酶,具有分解大豆蛋白的能力。我国传统工艺中,毛霉常被用来制作豆腐乳和豆豉。此外,许多毛霉还能产生草酸、乳酸、琥珀酸及甘油等有机化合物,有的还能产生脂肪酶、果胶酶和凝乳酶等酶类。
根霉
根霉属于接合菌亚门、接合菌纲、毛霉目、毛霉科中的根霉属。这种真菌的菌丝同样无隔膜,但具有分枝和假根结构。在营养菌丝体上,根霉会产生匍匐枝,这些匍匐枝的节间会形成特有的假根。从假根处向上丛生的是直立且不分枝的孢囊梗,顶端膨大形成圆形的孢子囊,囊内则产生孢囊孢子。
在显微镜下,根霉的菌落通常疏松或稠密,最初呈白色,随后可能变为灰褐色或黑褐色。根霉的假根结构是其显著特征之一,它们像植物的根部一样深入基质中,为真菌提供营养和支持。
根霉在工业生产中同样具有重要地位。我国最早利用根霉糖化淀粉(即阿明诺法)生产酒精。此外,根霉还能生产延胡索酸、乳酸等有机酸,以及芳香性的酯类物质。在生物技术领域,与根霉关系密切的黑根霉、华根霉和米根霉等种类被广泛应用于甾族化合物的转化和其他生物化学过程中。
曲霉
曲霉是发酵工业和食品加工业中的重要菌种之一,已被利用的近60种。它们广泛分布在谷物、空气、土壤和各种有机物品上,并以分生孢子进行繁殖。
在显微镜下观察,曲霉的菌丝同样无隔膜,且分枝较多。曲霉的分生孢子梗通常具有足细胞,并呈辐射状排列在菌丝体上。这些分生孢子梗的顶端会产生链状的分生孢子,这些孢子在形态和颜色上可能因种类而异。
曲霉在酿造业和食品加工方面发挥着巨大作用。它们能够分解蛋白质等复杂有机物,产生酒精、醋酸和其他风味物质。在现代工业中,曲霉还被用于生产各种酶制剂、有机酸以及农业上的糖化饲料。
然而,需要注意的是,有些曲霉种类能够产生对人体有害的真菌毒素。例如,生长在花生和大米上的某些曲霉种类能够产生黄曲霉毒素B1等致癌物质。因此,在食品生产和储存过程中需要严格控制曲霉的生长条件以防止毒素的产生。
青霉
青霉是子囊菌纲中的一属真菌,与曲霉属有亲缘关系。它们同样广泛分布在土壤、空气和各种有机物品上,并以分生孢子进行繁殖。青霉的代表种类之一是灰绿青霉,它很容易从土壤或空气中分离出来。
在显微镜下观察,青霉的菌丝具有横隔膜,细胞内通常为多核。青霉的营养菌丝伸入营养基质中吸取营养,而气生菌丝则伸向空气中。在气生菌丝上会产生简单的长而直立的分生孢子梗,这些梗的顶端会形成帚状的分生孢子簇。这些分生孢子在形态和颜色上可能因种类而异,但通常为青绿色或褐色。
青霉在医药制造和农业生产中具有重要意义。它们能够产生多种抗生素和其他生物活性物质,这些物质在抗菌、抗肿瘤和免疫调节等方面发挥着重要作用。此外,青霉还被用于生产有机酸和
- 上一篇: 掌握秘籍:轻松下载并畅玩英雄联盟!
- 下一篇: 欧冠决赛直播,精彩赛事不容错过,观看渠道全攻略!
































